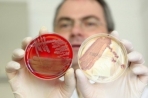

Костромские новости
-

07.11.2012
Игровой клуб в самом центре Костромы закрыли сотрудники полиции. Ярославские предприниматели организовали подпольный бизнес в заброшенном здании на проспекте Мира. Пришедшие в клуб сотрудники полиции обнаружили 5 игровых автоматов. Однако, как поясн... [ подробнее ] рейтинг материала: 0
рейтинг материала: 0
 комментарии: 0
комментарии: 0
-

07.11.2012
Торговца гашишем задержали костромские оперативники. По данным полицейских, молодой человек в течение нескольких месяцев ввозил в наш город наркотик из Москвы. Машину наркодилера оперативники задержали недалеко от железнодорожного вокзала. При обыск... [ подробнее ] рейтинг материала: -1
рейтинг материала: -1
 комментарии: 0
комментарии: 0
-

07.11.2012
В минувшие выходные более 50-ти жителей Шарьи обратились к медикам – с жалобами на температуру, тошноту и боли в желудке. Все они воспитанники, ученики и работники прогимназии №15. Четверым поставлен диагноз дизентерия. Шарьинская прогимназия ... [ подробнее ] рейтинг материала: 0
рейтинг материала: 0
 комментарии: 0
комментарии: 0
-

07.11.2012
Массовое заболевание детей в Шарье выявило еще ряд проблем в организации школьного питания в Костромской области. Одна из них – недобросовестное выполнение своих прямых обязательств районными властями. Согласно региональному закону, полноценны... [ подробнее ] рейтинг материала: 0
рейтинг материала: 0
 комментарии: 0
комментарии: 0
-

07.11.2012
Навести порядок в размещении рекламы в центре города, особенно на исторических зданиях, потребовал губернатор Костромской области Сергей Ситников в ходе еженедельного оперативного совещания. Глава региона отметил, что в центральной части города учас... [ подробнее ] рейтинг материала: 0
рейтинг материала: 0
 комментарии: 0
комментарии: 0
-

07.11.2012
8 ноября администрация Костромской области при поддержке Google запускает проект по развитию цифрового имиджа региона как привлекательного туристического направления. Цель проекта - продемонстрировать пользователям Сети туристический потенциал Костр... [ подробнее ] рейтинг материала: 0
рейтинг материала: 0
 комментарии: 0
комментарии: 0
-

07.11.2012
7 ноября в 14.00 Бизнес-центр Костромской области для учащихся и студентов образовательных учреждений пройдет «День открытых дверей». Сотрудники Бизнес-центра расскажут об основных направлениях организации своего бизнеса, а так же познак... [ подробнее ] рейтинг материала: 0
рейтинг материала: 0
 комментарии: 0
комментарии: 0
-

06.11.2012
Следственными органами Следственного комитета Российской Федерации по Костромской области завершено расследование уголовного дела в отношении 46-летней местной жительницы, обвиняемой в совершении преступления, предусмотренного ч. 1 ст. 30, ч. 3 ст. 33, п.п. &l... [ подробнее ] рейтинг материала: 0
рейтинг материала: 0
 комментарии: 0
комментарии: 0
-

06.11.2012
В период с 2 по 5 ноября 2012 года в инфекционное отделение Шарьинской окружной больницы в связи с плохим самочувствием было госпитализировано 22 учащихся муниципального образовательного учреждения «Прогимназия № 15» города Шарьи, 25 учащихся прохо... [ подробнее ] рейтинг материала: 0
рейтинг материала: 0
 комментарии: 0
комментарии: 0